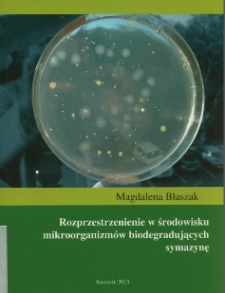
Rozprzestrzenienie w środowisku mikroorganizmów biodegradujących symazynę

Obiekt
Tytuł: Rozprzestrzenienie w środowisku mikroorganizmów biodegradujących symazynę
Współtwórca:
Zachodniopomorski Uniwersytet Technologiczny (Szczecin). ; Wydawnictwo Uczelniane. ; pbl
Wydawca:
Wydawnictwo Uczelniane Zachodniopomorskiego Uniwersytetu Technologicznego
Miejsce wydania:
Język:
pol ; eng ; ger ; Streszcz. ang. i niem.
Identyfikator zasobu:
oai:zbc.ksiaznica.szczecin.pl:54196
Źródło - sygn. oryginału:
OPAC WWW kat. online:
Prawa:
Umowa zawarta pomiędzy ZUT w Szczecinie i autorem
Lokalizacja oryginału:
Kolekcje, do których przypisany jest obiekt:
- ZBC POMERANIA > Nauka i dydaktyka - repozytorium
- ZBC POMERANIA > Nauka i dydaktyka - repozytorium > Zachodniopomorski Uniwersytet Technologiczny
- ZBC POMERANIA > Doktoraty i habilitacje
- ZBC POMERANIA > Zasób Zachodniopomorskiego Uniwersytetu Technologicznego
Data ostatniej modyfikacji:
2023-04-13
Data dodania obiektu:
2023-04-13
Liczba wyświetleń treści obiektu:
99
Wszystkie dostępne wersje tego obiektu:
https://zbc.ksiaznica.szczecin.pl/publication/56513
Wyświetl opis w formacie RDF:
Wyświetl opis w formacie OAI-PMH:
| Nazwa wydania | Data |
|---|---|
| Rozprzestrzenienie w środowisku mikroorganizmów biodegradujących symazynę | 2023-04-13 |